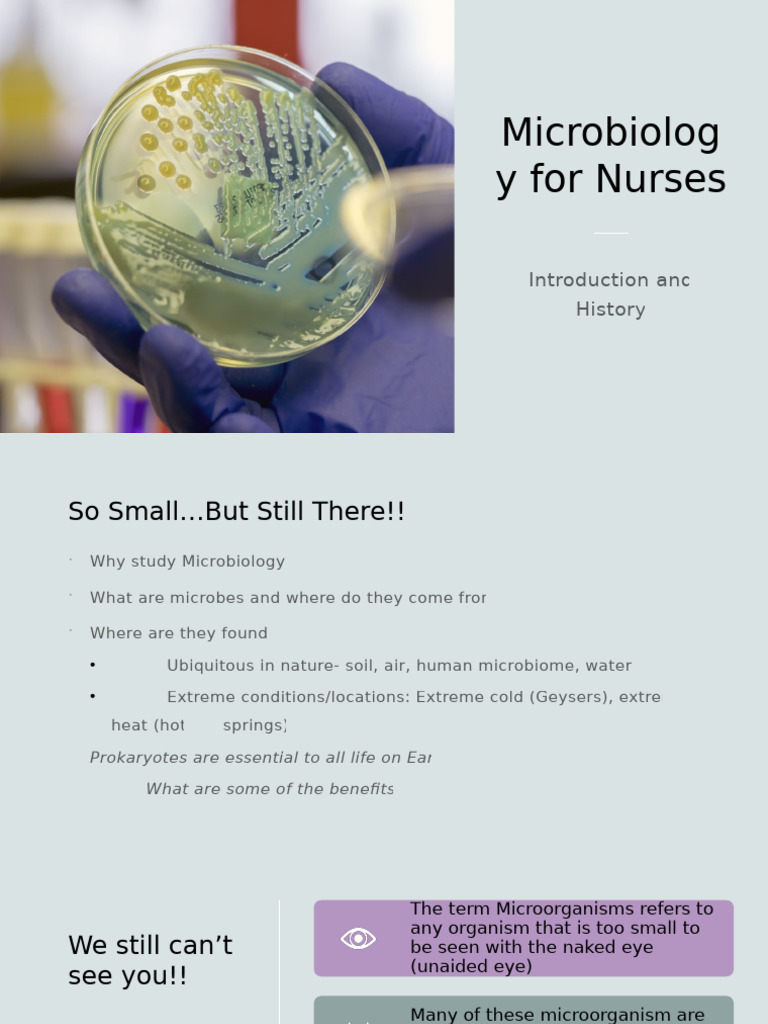
WEEK+1 +lecture+1 +Introduction+to+Microbiology | PDF

Explore the educational aspects of ppt - special topics in genomics lecture 1: introduction powerpoint through substantial collections of informative visual resources. facilitating comprehension through clear visual examples and detailed documentation. encouraging critical thinking and analytical skill development. Discover high-resolution ppt - special topics in genomics lecture 1: introduction powerpoint images optimized for various applications. Excellent for educational materials, academic research, teaching resources, and learning activities All ppt - special topics in genomics lecture 1: introduction powerpoint images are available in high resolution with professional-grade quality, optimized for both digital and print applications, and include comprehensive metadata for easy organization and usage. The ppt - special topics in genomics lecture 1: introduction powerpoint collection serves as a valuable educational resource for teachers and students. Cost-effective licensing makes professional ppt - special topics in genomics lecture 1: introduction powerpoint photography accessible to all budgets. Each image in our ppt - special topics in genomics lecture 1: introduction powerpoint gallery undergoes rigorous quality assessment before inclusion. Professional licensing options accommodate both commercial and educational usage requirements. Comprehensive tagging systems facilitate quick discovery of relevant ppt - special topics in genomics lecture 1: introduction powerpoint content. Diverse style options within the ppt - special topics in genomics lecture 1: introduction powerpoint collection suit various aesthetic preferences.